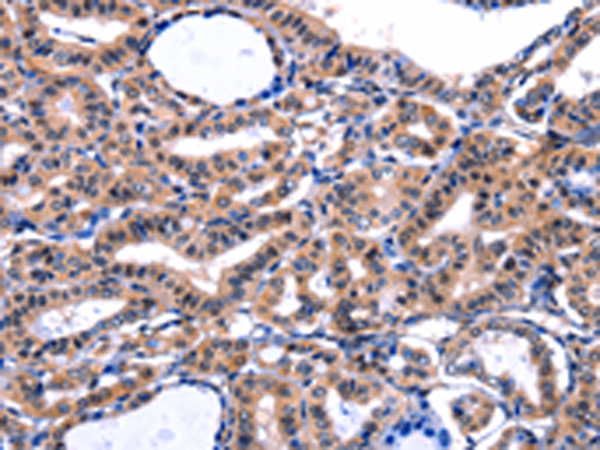
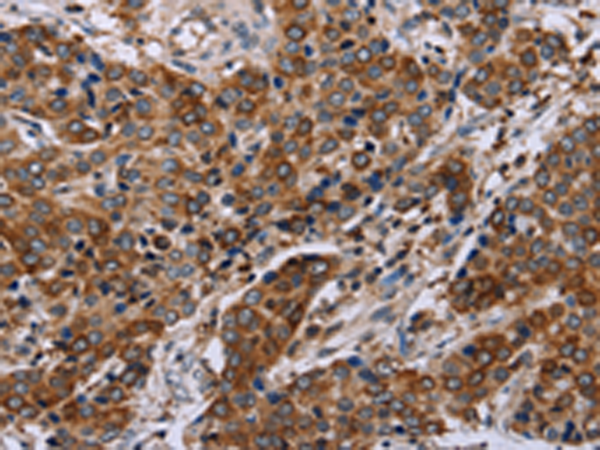
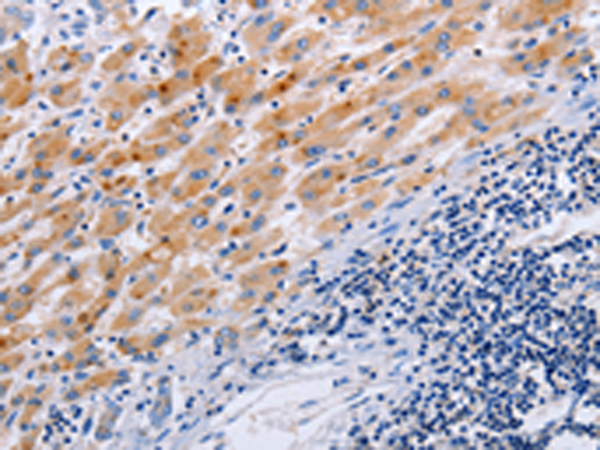

-
分类: 科研抗体货号: P10847别名: FBN, SGS, WMS, MASS, MFS1, OCTD, SSKS, WMS2, ACMICD, ECTOL1, GPHYSD2应用: IHC反应种属: Human, Mouse
-
分类: 科研抗体货号: P10848别名: BEK, JWS, BBDS, CEK3, CFD1, ECT1, KGFR, TK14, TK25, BFR-1, CD332, K-SAM应用: IHC反应种属: Human, Mouse
-
分类: 科研抗体货号: P10868别名: WHN, RONU, FKHL20应用: IHC反应种属: Human
-
分类: 科研抗体货号: P10845别名: hFAF1; CGI-03; HFAF1s; UBXD12; UBXN3A应用: WB,IHC反应种属: Human, Mouse, Rat
-
分类: 科研抗体货号: P10867别名: BPES, PFRK, POF3, BPES1, PINTO应用: WB反应种属: Human, Mouse
-
分类: 科研抗体货号: P10880别名: PBP; Pc-1; TRPP1应用: IHC反应种属: Human, Mouse
-
分类: 科研抗体货号: P10866别名: FKH6, FKHL11, FREAC7应用: WB反应种属: Human, Mouse
-
分类: 科研抗体货号: P10879别名: NHE3应用: IHC反应种属: Human, Mouse, Rat
-
分类: 科研抗体货号: P10865别名: FOXK1L应用: WB反应种属: Human, Mouse
-
分类: 科研抗体货号: P10876别名: MLSN1, CSNB1C, LTRPC1应用: IHC反应种属: Human, Mouse, Rat

鄂公网安备42018502007531号
鄂公网安备42018502007531号

